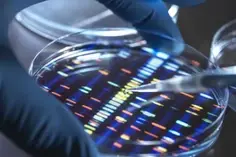
16818077030_TWI.webp

À la fin du 20e siècle, l’émergence d’un « devoir de mémoire » a accentué les tensions.
Archives février 2023
Tous les articles parus sur scienceshumaines.com en février 2023.
Faut-il déboulonner les statues ?

Certains héros du passé ont contribué à la colonisation et à l'esclavage. Jusqu’où faut-il revisiter notre mémoire collective ?
L'appropriation culturelle, une captation indue ?

Des motifs et pratiques culturelles sont parfois exploités économiquement par d’autres pays, plus riches et plus puissants. Un phénomène de plus en plus dénoncé.
Comment restituer son patrimoine à l'Afrique ? Entretien avec Claire Bosc-Tiessé

Beaucoup d'objets africains ont été pillés pendant la colonisation. Les États européens entreprennent de rendre ces œuvres, souvent dotées d’une forte valeur symbolique.
Qui va payer la dette écologique ?

Nos modes de productions épuisent les ressources naturelles. La notion de dette écologique découle de cette prise de conscience.
Comment la seconde main est devenue chic

Le marché de la friperie est en pleine expansion en France. Fondé sur des arguments écologiques et sentimentaux, il séduit des acheteurs en quête de sobriété, mais encourage paradoxalement la surconsommation.
Des langues à reconquérir Entretien avec James Costa
Pour revitaliser une langue, il faut un soutien institutionnel et une volonté collective.
Que transmet-on quand on choisit un prénom ?
Le prénom transmet à lui seul une multitude de signaux, qui échappent parfois aux parents.
«Une recette de cuisine vaut parfois autant qu'un bijou» Entretien Margaret Josion-Portail
À l’heure des tutos internet, les trucs et astuces de nos aïeux gardent toute leur valeur. Outre des connaissances pratiques, ils véhiculent toute une expérience.
Le métissage en héritage Entretien avec Solène Brun
Comment coiffer les cheveux crépus de sa fille quand on est une mère blanche ?
Croit-on en Dieu par tradition ?

Adhérer à une religion, c'est s'inscrire dans une lignée croyante et en transmettre l'enseignement. Une exigence qui se heurte aujourd’hui à la sécularisation des sociétés.
Patrimoine familial : des biens et des liens

Meubles, bijoux et vaisselle qui circulent d'une génération à l'autre ne sont pas des cadeaux comme les autres. Ils consacrent des devoirs et des liens familiaux.
Grandir orphelin, une épreuve et une force

La perte d’un ou de ses deux parents a des répercussions à long terme sur la vie d’un enfant. Comment se construit-on en leur absence ?
Les idées politiques, une affaire de famille ?

Contexte économique, école, médias… Pour les jeunes, la formation d’une identité politique découle de négociations entre influences familiales et expérimentations personnelles.
Que transmettre quand on a tout quitté ?

Le projet migratoire est en lui-même un héritage, pas toujours facile à gérer. Transmettre une culture ou des biens s’avère plus difficile lorsque la famille habite différents pays.
Fratrie : quand la succession fait mal

Une succession peut faire voler en éclat la belle concorde qui semblait régner entre frères et sœurs. Plus que de l’argent, elle remet en cause le rang de chacun dans la famille.
La France, une société d'héritiers ? Entretien avec Mélanie Plouviez

Difficile de résorber les inégalités de patrimoine sans repenser cette institution en profondeur. Les débats du 19e siècle, plus riches qu’aujourd’hui, peuvent nous inspirer à cet égard.
Comment transmettre la mémoire ouvrière ?

Menacée par la désindustrialisation, la culture ouvrière se transmet tant par les acteurs et organisations qu’au travers d’initiatives d’éducation populaire.
Compétences ou connaissances, qu'enseigner à l'école ?

Le vieil affrontement entre les tenants de l’instruction et ceux de l’éducation resurgit à travers de virulentes critiques de la notion de compétences.
De l'hérédité à l'héritage

Patrimoine biologique, matériel, culturel… Dans toutes les sociétés, la notion de transmission se décline au pluriel et comporte une forte charge symbolique.
Sommes-nous ce que nos gènes font de nous ?
Notre patrimoine biologique est le fruit de multiples influences… La géographie, l’histoire mais aussi la sociologie se lisent ainsi dans notre génome.
Comment se transmettent les langues ?

La transmission des langues est avant tout sociale. Leur naissance ou leur disparition est liée aux politiques linguistiques ou aux dominations économiques.
Être soi-même, c'est être plusieurs

Nous sommes à la fois un et multiple par les expériences que nous vivons. Une situation compliquée à vivre face aux injonctions à l’authenticité.
Savoir s'affirmer
Aider les personnes qui manquent de confiance en elles à s’exprimer et exercer leurs droits, c’est l’objectif des techniques d’affirmation de soi, nées aux États-Unis dans les années 1960.
Terres plates et lunes creuses

Sebastian Dieguez, chercheur en psychologie cognitive, montre pourquoi le complotisme et les vérités alternatives ne sont pas des croyances comme les autres, mais des souhaits.

















